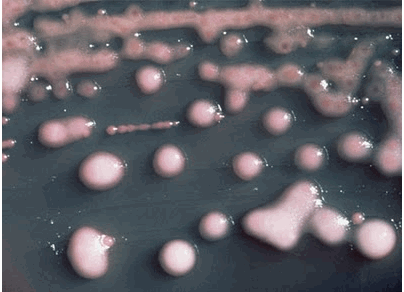

超級細菌 NDM-1
人氣(14787)
源自於南亞的新型態「超級細菌」NDM-1 (New Delhi metallo-β-lactamase 1;新德里產金屬-β-內胺(酉每)-1),不怕抗生素且能存活於不同菌種,可以在細菌中自由複製和移動,使得它擁有驚人的傳播和變異潛能,輕易就能依附在其他病毒上,一旦擴散,殺傷力很強,因此有另一個別名-「末日細菌」。
已有發現和大腸桿菌以及肺炎克雷伯菌(K pneumoniae)結合的病例,導致泌尿道感染或肺炎,患者染病後會出現小便疼痛、傷口感染和發燒等症狀;但如果是和危險性病毒結合,一旦侵入血液,恐會變成無法醫治的人傳人病毒。
發現的病例中,主要都是經由手術傳染,透過人體接觸或共用物品,依附到其他病毒上傳播,醫院成為最容易感染的場所。
超級細菌 NDM-1,除了替加環素(tigecycline)與克痢黴素(colistin)外,對絕大抗生素都具備高度抗藥性,就連對最廣效的抗生素碳青黴烯類(carbapenem)都具抗藥性。

|
|
|
|